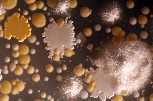
Fermented frenzy: London Gastronomy Seminars talk mouldy cheese

Paulo Barbosa, Macau Daily Times Two well-known chefs from Portugal have opened a new restaurant in Macau. Luís Américo says “it was very...
MoreNose to Tail Fortnight: offally good food experiences in London
By Leah Hyslop, TheTelegraph Whimsical pop-up restaurateurs Jamie Hazeel and Lalie Jacout certainly aren’t interested in broaching the subject of...
MoreWeek of Peruvian delights beginning this Sunday
Gulf Times Some 35 Peruvian dishes will be featured in a week-long food festival from June 9 to 15 at the Latino Restaurant of Sheraton Doha...
MoreGastronomy drawing more and more visitors to Peru
by Andean Air Mail & PERUVIAN TIMES Peruvian food is increasingly becoming a draw for tourists to the Andean nation. The National Tourism...
MorePoland’s food scene grows in stature
YouTube Though Poland is not often associated with gastronomy, the country’s food scene is expanding fast. Growing numbers of organic food...
MoreGastronomy festival gets underway in central Mexico
GlobalPost A gastronomy festival got underway Saturday in the central Mexican state of Guanajuato, where thousands of people will enjoy the...
MoreArchestratus and the Secrets of Ancient Greek Gastronomy
Ancient Greek poet and philosopher of Gela or Syracuse Archestratus was the first to approach cooking as an art. The origin of modern day word...
MoreManaging Spontaneity
An ART-idea conversation with the authors of Eventful Cities, Greg Richards and Robert Palmer, took place in Barcelona on 17th April 2013. The...
MoreAnna Lindh Forum, 4-7 April 2013
The Anna Lindh Mediterranean Forum took place in Marseille from 4 – 7 April. 1,500 representatives of civil society, from 44 countries from...
MoreFestival whets the appetite for new food experiences
Galway City tribune Good food starts with good suppliers,” says Heather Flaherty, head chef of McCambridge’s Restaurant on Shop Street, as she...
MoreGreek gastronomy in Brussels
Travel Daily News Following the success of Brusselicious, the Greek National Tourism Organisation in Belgium and SETE (the Association of Greek...
MoreFermented frenzy: London Gastronomy Seminars talk mouldy cheese
Blue cheese! Beer! Sourdough! Miso! Is it fermentation that creates the flavours you really crave? Then here’s your chance to find our more about...
More